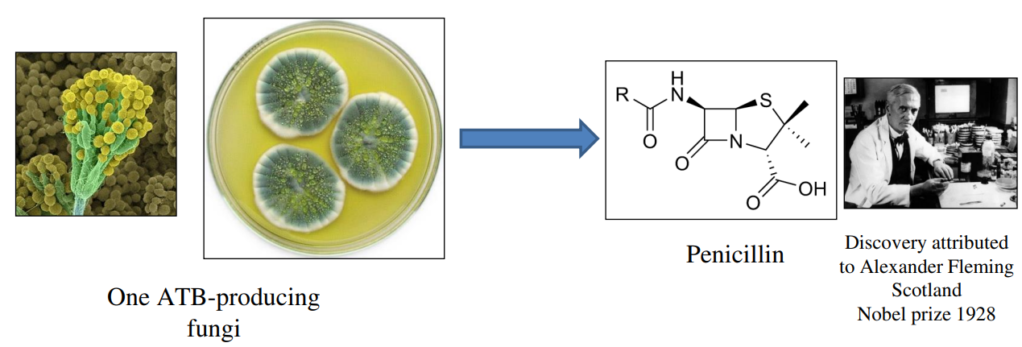

C3.2.1 – Pathogens as the Cause of Infectious Diseases
🔑 What Are Pathogens?
A pathogen is an organism or virus that causes disease by infecting a host.
Common types of pathogens include:
- Viruses (e.g., HIV, measles virus)
- Bacteria (e.g., Vibrio cholerae, Mycobacterium tuberculosis)
- Fungi (e.g., Candida species)
- Protists (e.g., Plasmodium that causes malaria)
- Archaea are microorganisms but, importantly, are not known to cause diseases in humans.
🧬 Disease and Hosts
A disease is a pathological condition caused by infection, genetic defects, or environmental stress.
Hosts are organisms that are infected by pathogens. Humans are hosts to many pathogens.
🌍 Types of Diseases
- Infectious (Communicable) diseases: Can spread from one individual to another, e.g., cholera, malaria, tuberculosis, HIV/AIDS, measles.
- Non-infectious (Non-communicable) diseases: Cannot be transmitted between individuals, e.g., cancer, cardiovascular disease.
🕵️♂️ Historical Significance: Careful Observation and Disease Control
In the 19th century, epidemics like childbed fever in Vienna and cholera in London were studied carefully.
Observations during these outbreaks led to key breakthroughs in understanding how infections spread and how to control them, improving public health worldwide.
🚪 Avenues of Pathogen Entry
Pathogens enter the body through:
- The digestive system (e.g., contaminated food or water)
- The respiratory system (e.g., inhaling droplets)
- The urogenital tract
- Breaks in the skin (cuts, insect bites)
🚀 Routes of Infection and Attack
Once inside, pathogens may spread through:
- The circulatory system (bloodstream)
- The lymphatic system
🧬 Self vs Non-Self Recognition
- Each individual’s cells display unique proteins and glycoproteins on their surface, called the Major Histocompatibility Complex (MHC).
- The immune system distinguishes between self (the body’s own cells) and non-self (foreign cells or molecules).
- Foreign molecules, called antigens, trigger an immune response, which involves production of specific antibodies to eliminate the pathogen.
🛡️ Defence Against Pathogens
Animals have three lines of defence to protect against pathogens. If a pathogen bypasses one line, it faces the next.
These defence mechanisms work together as an integrated immune system to protect the host from infectious diseases.
Pathogens are viruses, bacteria, fungi, or protists that cause infectious diseases by entering and multiplying within hosts. Understanding pathogen entry and the immune system’s recognition of non-self molecules is essential for controlling infectious diseases.
C3.2.2 – Skin and Mucous Membranes as a Primary Defence
Skin: The First Line of Defence
The skin acts as a physical barrier preventing pathogens from entering the body.
It is made of tightly packed dead cells in the outer layer (epidermis), which are difficult for microbes to penetrate.
The skin also produces chemical barriers such as:
- Sebum: An oily substance that inhibits growth of bacteria and fungi by making the skin slightly acidic.
- Sweat: Contains antimicrobial substances like enzymes that break down bacterial cell walls.
- Skin is dry and salty, creating an environment hostile to many pathogens.
Mucous Membranes: Protecting Internal Surfaces
Mucous membranes line body openings that are exposed to the environment such as:
- Respiratory tract (nose, trachea)
- Digestive tract (mouth)
- Urogenital tract
These membranes secrete mucus, a sticky fluid that:
- Traps pathogens and particles
- Contains antimicrobial enzymes like lysozyme which destroy bacteria
- Cilia (tiny hair-like structures) in the respiratory tract help move mucus and trapped pathogens out of the lungs.
🔹 Summary
Both skin and mucous membranes form the body’s primary, non-specific defence against infection.
They prevent pathogens from entering and establishing infection in the body through physical blocking and chemical protection.
C3.2.3 – Sealing of Cuts in Skin by Blood Clotting
🔹 Blood Clotting Process
- When the skin is cut or damaged, platelets at the injury site release clotting factors.
- These clotting factors trigger a cascade pathway – a series of chemical reactions that amplify the response.
- The cascade results in the enzyme thrombin converting fibrinogen (a soluble protein in blood plasma) into fibrin (an insoluble protein).
- Fibrin forms a mesh network that traps erythrocytes (red blood cells) and platelets, creating a blood clot.
- This clot acts as a temporary seal to prevent further blood loss and blocks entry of pathogens.
🔹 Summary
Blood clotting rapidly seals cuts by forming a fibrin mesh that traps blood cells, preventing infection and blood loss.
The process is triggered by clotting factors released from platelets and involves a cascade to amplify the response.
C3.2.4 – Differences Between Innate and Adaptive Immune Systems
⚔️ Innate Immune System
- Responds immediately and non-specifically to broad categories of pathogens (like bacteria or viruses).
- The response is the same throughout an organism’s life – it does not improve or adapt with repeated infections.
- Includes phagocytes, which engulf and digest pathogens as a first line of defence.
🎯Adaptive Immune System
- Responds specifically to particular pathogens.
- Builds up a memory of pathogens encountered, so subsequent responses to the same pathogen are faster and stronger.
- This system changes and improves during the organism’s life.
📊 Summary Table
| Feature | Innate Immune System | Adaptive Immune System |
|---|---|---|
| Response Speed | Immediate | Slower (initially) |
| Specificity | Broad categories of pathogens | Specific to particular pathogens |
| Memory | No | Has immunological memory |
| Changes Over Lifetime | No | Yes, improves with exposure |
| Example Component | Phagocytes | Antibodies, T cells (not required to know details) |
C3.2.5 – Infection Control by Phagocytes
What Are Phagocytes?
Phagocytes are a type of white blood cell involved in the body’s first line of defense against infections. Their main role is to find, engulf, and destroy invading pathogens like bacteria and viruses.
🚶♂️ Amoeboid Movement to Infection Sites
Phagocytes move from the bloodstream into tissues where infection occurs by a special crawling movement called amoeboid movement.
This movement allows them to squeeze through blood vessel walls and travel toward chemical signals released by pathogens or damaged cells.
🔍 Recognition of Pathogens
Phagocytes recognize pathogens by detecting molecules on the pathogen’s surface that are foreign to the body.
These molecules are called antigens or pathogen-associated molecular patterns (PAMPs).
Engulfment by Endocytosis (Phagocytosis)
Once a pathogen is recognized, the phagocyte surrounds it with its cell membrane and engulfs it into a vesicle called a phagosome.
This process is called phagocytosis.
🧪 Digestion Using Lysosomes
Lysosomes inside the phagocyte contain digestive enzymes.
The phagosome fuses with lysosomes, forming a phagolysosome.
The enzymes break down the pathogen into harmless components, effectively destroying it.
🌟 Summary of the Process
- Phagocyte detects chemical signals from infected tissue.
- Moves toward infection site via amoeboid movement.
- Recognizes and binds to the pathogen.
- Engulfs pathogen by phagocytosis into a phagosome.
- Phagosome fuses with lysosomes.
- Digestive enzymes destroy the pathogen.
⚠️ Why Phagocytes Are Important
They clean up infections early before the adaptive immune system is activated.
They prevent pathogens from spreading and help activate other immune cells by presenting pieces of the pathogen.
Phagocytes use amoeboid movement to reach infection sites, recognize pathogens by their surface markers, engulf them by endocytosis, and destroy them with enzymes from lysosomes, playing a vital role in infection control.
C3.2.6 – Lymphocytes in the Adaptive Immune System
🔍 What Are Lymphocytes?
Lymphocytes are specialized white blood cells essential for the adaptive immune response, which targets specific pathogens.
They circulate in the blood and are also concentrated in structures called lymph nodes.
Types of Lymphocytes
The two main types are B-lymphocytes (B-cells) and T-lymphocytes (T-cells).
This note focuses on B-lymphocytes involved in antibody production.
B-Lymphocytes and Antibody Production
Each individual has a huge variety of B-lymphocytes, each capable of producing a unique antibody that binds specifically to one kind of antigen (pathogen marker).
This diversity allows the immune system to recognize and respond to an enormous range of pathogens.
🔄 Lymphocyte Circulation and Cooperation
B-lymphocytes circulate in the blood and lymphatic system and gather in lymph nodes.
When a B-lymphocyte encounters its specific antigen, it is activated, often with the help of T-lymphocytes, to multiply and produce large amounts of the matching antibody.
⚙️ Role of Antibodies
Antibodies bind to antigens on pathogens, marking them for destruction by other immune cells.
This is a key part of the adaptive immune response, providing targeted defense.
🌟 Summary of Key Points
- Lymphocytes include B-cells that produce specific antibodies.
- They circulate in blood and concentrate in lymph nodes.
- Each B-cell produces one unique antibody type.
- Cooperation between lymphocytes enhances immune defense.
Lymphocytes in the adaptive immune system circulate in blood and lymph nodes. B-lymphocytes each produce a unique antibody, allowing the body to target a vast range of pathogens effectively.
C3.2.7 – Antigens as Recognition Molecules That Trigger Antibody Production
What Are Antigens?
Antigens are molecules that the immune system recognizes as foreign and that trigger an immune response.
Most antigens are proteins or glycoproteins (proteins with carbohydrate groups attached).
🌍 Location of Antigens
Antigens are usually found on the outer surfaces of pathogens such as bacteria, viruses, and fungi.
Because of their location, they serve as the “identity tags” that the immune system uses to detect invaders.
🩸 Antigens on Erythrocytes (Red Blood Cells)
Antigens are also present on the surface of erythrocytes (red blood cells).
Blood group antigens (like ABO and Rh) can cause immune reactions if blood from one person is transfused into another person with a different blood group.
These antigens can stimulate antibody production, leading to rejection of the transfused blood.
Role of Antigens in Antibody Production
When the immune system detects antigens, it triggers B-lymphocytes to produce specific antibodies that can bind to these antigens.
This is a key step in targeting and eliminating pathogens or foreign cells.
🌟 Summary of Key Points
- Antigens are mostly proteins or glycoproteins on the surface of pathogens or cells.
- They are the trigger for antibody production.
- Antigens on red blood cells can cause immune reactions in blood transfusions.
Antigens, mainly glycoproteins on pathogen or cell surfaces, act as recognition molecules that trigger the production of specific antibodies to fight infection or foreign cells.
C3.2.8 – Activation of B-lymphocytes by Helper T-lymphocytes
🔑 Antigen Specificity
Both B-lymphocytes (B-cells) and helper T-lymphocytes (helper T-cells) are antigen-specific.
This means each B-cell and helper T-cell recognizes a specific antigen.
⚡ Activation of B-lymphocytes
B-cells produce antibodies and develop into memory cells only after activation.
Activation requires two key events:
- Direct interaction with the specific antigen — the B-cell’s receptor binds to its matching antigen.
- Contact with a helper T-cell that has also been activated by the same antigen.
This interaction ensures that B-cells only respond to genuine threats, preventing unnecessary antibody production.
Role of Helper T-cells
Helper T-cells recognize the antigen presented by antigen-presenting cells (APCs) and become activated.
Activated helper T-cells then bind to the B-cell presenting the same antigen, releasing signals (cytokines) that stimulate the B-cell.
This cooperation triggers the B-cell to multiply and differentiate into plasma cells that secrete antibodies and memory B-cells for long-term immunity.
🌟 Summary of Key Points
- B-cells and helper T-cells are both antigen-specific.
- B-cell activation requires antigen binding and helper T-cell contact.
- Activated B-cells produce antibodies and form memory cells.
B-lymphocytes are activated to produce antibodies and memory cells only after binding their specific antigen and receiving help from helper T-lymphocytes activated by the same antigen.
C3.2.9 – Multiplication of Activated B-lymphocytes to Form Clones of Antibody-Secreting Plasma Cells
Low Initial Numbers
The body contains a very small number of B-cells that can respond to any one specific antigen.
These specific B-cells must increase in number to mount an effective immune response.
Clonal Expansion
- Once a B-cell is activated (by antigen binding and helper T-cell interaction), it divides by mitosis.
- This process is called clonal expansion or clonal multiplication.
- It produces many identical daughter cells (clones) all specific for the same antigen.
🧪 Plasma Cells and Antibody Production
Most of these clones differentiate into plasma cells.
Plasma cells are specialized for producing and secreting large amounts of antibodies specific to the antigen.
This ensures that sufficient antibody is available to neutralize or mark the pathogen for destruction.
Memory Cells
Some clones become memory B-cells, which persist in the body to provide rapid response to future infections by the same pathogen.
🌟 Summary of Key Points
- Activated B-cells divide by mitosis to increase their numbers.
- This multiplication produces many plasma cells capable of antibody secretion.
- Memory cells are also produced for long-term immunity.
Activated B-lymphocytes multiply by mitosis to form clones of plasma cells, producing large quantities of antibodies to fight infection, while some become memory cells for future immunity.
C3.2.10 – Immunity as a Consequence of Retaining Memory Cells
🔍 What is Immunity?
Immunity is the ability of the body to eliminate an infectious disease.
It means the body can resist or fight off infection caused by a specific pathogen.
Role of Memory Cells
Immunity is due to the long-term survival of memory lymphocytes (both B-cells and T-cells).
These memory cells “remember” the specific antigen of a pathogen encountered during the first infection or vaccination.
They persist in the body for years or even a lifetime.
⚔️ Rapid and Effective Response
Upon re-exposure to the same pathogen, memory cells quickly recognize the antigen.
This triggers a faster and stronger immune response compared to the first infection.
Memory B-cells rapidly divide and produce antibodies, often neutralizing the pathogen before symptoms develop.
🌟 Summary of Key Points
- Immunity depends on the presence of memory lymphocytes.
- Memory cells enable the body to respond rapidly to repeat infections.
- This long-lasting immunity protects against reinfection by the same pathogen.
Immunity arises because memory lymphocytes persist long-term, allowing the body to mount a rapid and effective response upon re-exposure to a specific infectious agent.
C3.2.11 – Transmission of HIV in Body Fluids
🔑 What is HIV?
HIV stands for Human Immunodeficiency Virus.
It attacks the immune system, specifically targeting helper T-lymphocytes, weakening the body’s ability to fight infections.
💧 Body Fluids That Can Transmit HIV
HIV is transmitted through certain body fluids that contain infected cells or free virus particles. These include:
- Blood
- Semen
- Vaginal secretions
- Breast milk
- Rectal fluids
⚠️ Common Mechanisms of HIV Transmission
| Mechanism | Description | Example |
|---|---|---|
| Unprotected sexual contact | Exchange of bodily fluids during vaginal, anal, or oral sex | Vaginal intercourse without condom |
| Blood-to-blood contact | Direct contact with infected blood | Sharing needles for injecting drugs |
| Mother-to-child transmission | From mother to baby during pregnancy, childbirth, or breastfeeding | Transmission through breast milk or placenta |
| Blood transfusions | Receiving contaminated blood or blood products | Unsafe transfusions in some healthcare settings |
🚫 Not Transmitted By:
- Saliva
- Sweat
- Tears
- Casual contact such as hugging, shaking hands, or sharing utensils
🔄 Prevention
- Use of condoms during sexual activity
- Use of sterile needles and syringes
- Screening of blood products before transfusion
- Antiretroviral therapy (ART) for HIV-positive pregnant women to reduce mother-to-child transmission
HIV is transmitted mainly through infected blood, sexual fluids, and from mother to child. Understanding these mechanisms helps prevent the spread of the virus.
C3.2.12 – Infection of Lymphocytes by HIV with AIDS as a Consequence
HIV Targets Specific Lymphocytes
- HIV specifically infects helper T-lymphocytes (also called CD4+ T cells).
- These lymphocytes are crucial for coordinating the immune response, especially the activation of B-lymphocytes that produce antibodies.
⚙️ How HIV Infects Lymphocytes
- HIV binds to the CD4 receptor on helper T-cells and enters the cell.
- The virus replicates inside the lymphocyte, eventually causing cell death either by virus-induced lysis or immune destruction of infected cells.
- Over time, this leads to a progressive decline in helper T-cell numbers.
🛡️ Consequences of Lymphocyte Infection
With fewer helper T-cells, the immune system becomes less effective at:
- Activating B-lymphocytes to produce specific antibodies.
- Coordinating other immune responses against pathogens.
This immunodeficiency leads to increased susceptibility to opportunistic infections and certain cancers.
⚠️ AIDS: The Advanced Stage of HIV Infection
- AIDS stands for Acquired Immunodeficiency Syndrome.
- It develops when the immune system is severely weakened due to the loss of helper T-cells.
- People with AIDS are vulnerable to infections that a healthy immune system would normally control.
HIV infects and kills helper T-lymphocytes, weakening the immune system. The resulting immunodeficiency leads to AIDS, marked by increased vulnerability to infections and disease.
C3.2.13 – Antibiotics and Their Specificity
🦠 How Antibiotics Work
Antibiotics are chemicals that specifically target processes unique to bacteria, such as:
- Cell wall synthesis (e.g., penicillin inhibits bacterial transpeptidases needed to build the cell wall).
- Protein synthesis using bacterial ribosomes (which differ from eukaryotic ribosomes).
- DNA replication or metabolic pathways exclusive to bacteria.
🧬 Why Antibiotics Don’t Affect Eukaryotic Cells
Eukaryotic cells (such as human cells) lack the bacterial cell wall and have different ribosomes and metabolic enzymes.
Antibiotics target bacterial structures or enzymes absent in eukaryotic cells, minimizing harm to human cells.
🚫 Why Antibiotics Don’t Work on Viruses
- Viruses do not carry out their own metabolic processes; instead, they hijack the host’s (human) cellular machinery to replicate.
- Viruses lack cell walls, ribosomes, and metabolic pathways that antibiotics target.
- Because viruses replicate inside host cells, antibiotics cannot selectively target viruses without damaging host cells.
- Treatment of viral infections typically requires antiviral drugs that specifically interfere with viral replication mechanisms.
Antibiotics kill or inhibit bacteria by targeting bacterial-specific structures and processes, which human cells lack. They are ineffective against viruses because viruses use host cell machinery for replication and lack bacterial targets.
C3.2.14 – Evolution of Antibiotic Resistance

⚠️ Development of Antibiotic Resistance
Pathogenic bacteria can evolve resistance to antibiotics through random mutations or by acquiring resistance genes via horizontal gene transfer (e.g., plasmids).
When antibiotics are used, sensitive bacteria are killed, but resistant bacteria survive and multiply, leading to strains resistant to multiple antibiotics (multiresistant bacteria).
🔄 Why Careful Use of Antibiotics Is Crucial
Overuse and misuse (e.g., unnecessary prescriptions, incomplete courses) increase selective pressure favoring resistant strains.
Careful antibiotic stewardship – prescribing antibiotics only when needed and completing full courses – helps slow the spread of resistance.
🔬 New Research and Techniques
Advances in biotechnology enable searching chemical libraries to discover novel antibiotics.
New techniques open new avenues for developing antibiotics effective against resistant bacteria, vital for future treatment.
Antibiotic resistance evolves through natural selection, making some bacteria survive antibiotic treatment. Responsible antibiotic use is essential to slow resistance. Innovative research, like chemical library screening, is promising for discovering new antibiotics.
C3.2.15 – Zoonoses: Infectious Diseases Transferred from Animals to Humans
What Are Zoonoses?
Zoonoses are infectious diseases that can transfer from animals (other species) to humans.
They are important because many serious human diseases originally came from animals.
🌍 Prevalence of Zoonoses in Humans
A large proportion of human infectious diseases are zoonotic in origin.
These diseases can spread through various modes such as direct contact, bites, insect vectors, or contaminated food and water.
🦠 Examples of Zoonotic Diseases
| Disease | Animal Source | Mode of Transmission | Key Facts |
|---|---|---|---|
| Tuberculosis (TB) | Cattle (Mycobacterium bovis) | Airborne droplets from infected animals | Can spread from cattle to humans; mainly lung infection |
| Rabies | Infected mammals (dogs, bats) | Bite or saliva contact | Fatal if untreated; affects nervous system |
| Japanese Encephalitis | Pigs and birds | Mosquito bites (vector-borne) | Causes brain inflammation; common in Asia |
| COVID-19 | Likely bats or other wild animals | Respiratory droplets and close contact | Recently emerged; caused global pandemic |
🌡️ Modes of Infection in Zoonoses
- Direct contact: Handling or bites from infected animals (e.g., rabies).
- Vectors: Insects like mosquitoes can carry pathogens from animals to humans (e.g., Japanese encephalitis).
- Airborne transmission: Inhalation of droplets from animals (e.g., tuberculosis).
- Contaminated food/water: Consumption of animal products can sometimes transfer pathogens.
⚠️ Impact of Zoonoses: The Case of COVID-19
COVID-19 is caused by SARS-CoV-2, a virus that likely originated in animals (possibly bats) and then spread to humans.
It shows how zoonoses can have profound global health and social impacts, causing pandemics and overwhelming healthcare systems.
Zoonoses are diseases that jump from animals to humans, with many human infections tracing back to animal origins. They spread via bites, vectors, or contaminated air and can cause major health crises, such as COVID-19. Understanding zoonoses helps in preventing and controlling outbreaks.
C3.2.16 – Vaccines and Immunization
What Are Vaccines?
Vaccines are substances used to stimulate the immune system to develop protection (immunity) against a specific disease-causing pathogen.
They contain antigens or genetic material (DNA or RNA) that code for antigens but do not cause the disease.
⚙️ How Do Vaccines Work?
The immune system recognizes the antigens from the vaccine as foreign.
This triggers an immune response:
- Production of antibodies specific to the pathogen.
- Creation of memory cells that remember the pathogen for faster response if exposed again.
- Immunity develops without the person becoming ill.
🧬 Types of Vaccines
- Whole Pathogen Vaccines: Contain weakened (attenuated) or inactivated pathogens.
- Subunit Vaccines: Contain only parts of the pathogen (antigens).
- mRNA or DNA Vaccines: Contain genetic material that instructs cells to produce the antigen (e.g., some COVID-19 vaccines).
🛡️ Importance of Immunization
Protects individuals by building immunity before exposure.
Contributes to herd immunity, reducing disease spread in the community.
Essential for controlling and eliminating infectious diseases worldwide.
Vaccines stimulate the immune system to build protection against specific pathogens safely, using antigens or genetic material. Immunization helps prevent diseases and protects communities by reducing the spread of infections.
C3.2.17 – Herd Immunity and the Prevention of Epidemics
What Is Herd Immunity?
- Herd immunity happens when a large enough proportion of a population becomes immune to an infectious disease.
- Immunity can come from vaccination or previous infection.
- When enough people are immune, the disease struggles to spread, protecting even those who are not immune.
Population Interdependence
- Members of a population depend on each other to build herd immunity.
- The more people immune, the lower the chance that an infected person will transmit the disease.
- This breaks chains of transmission and can prevent outbreaks or epidemics.
🧪 Scientific Process and Vaccine Safety
- Vaccines undergo rigorous testing and evaluation before approval.
- Scientists publish research so others can check and repeat studies, ensuring reliability.
- Media may report findings before full evaluation, so it’s important to understand that:
- Science develops pragmatic truths (best current knowledge) rather than absolute certainty.
- Side effects from vaccines are very rare but can occur.
- Awareness of this helps people make informed decisions about vaccination.

🦠 Why Herd Immunity Matters
- Protects vulnerable individuals who can’t be vaccinated (e.g., very young, immunocompromised).
- Controls and eventually eradicates infectious diseases (e.g., smallpox).
- Reduces the overall burden of disease on society.
Herd immunity protects whole communities by limiting disease spread when enough people are immune. Scientific research ensures vaccine safety, though complete certainty is rare. Understanding this helps prevent epidemics and safeguards vulnerable populations.
C3.2.18 – Evaluation of Data Related to the COVID-19 Pandemic
🔍 Understanding Data During the Pandemic
Data about COVID-19 cases, recoveries, deaths, and vaccinations have been tracked worldwide.
Evaluating this data helps understand the progression of the pandemic and the impact of interventions like lockdowns and vaccines.
📈 Calculating Percentage Change
Percentage change shows how much a value increases or decreases over time.
Formula:
\[ \text{Percentage change} = \frac{\text{New value} – \text{Old value}}{\text{Old value}} \times 100 \]
Example: If daily cases rise from 1,000 to 1,200:
\[ \frac{1200 – 1000}{1000} \times 100 = 20\% \text{ increase} \]
⚖️ Calculating Percentage Difference
Percentage difference compares two values to see how different they are, regardless of which is bigger.
Formula:
\[ \text{Percentage difference} = \frac{|\text{Value 1} – \text{Value 2}|}{\text{Average of values}} \times 100 \]
Example: Comparing 800 and 1,000 daily cases:
\[ \frac{|800 – 1000|}{(800 + 1000)/2} \times 100 = \frac{200}{900} \times 100 \approx 22.2\% \]
🧪 Application of These Skills
- Students can use percentage change to track trends like rising or falling infection rates.
- Percentage difference can help compare data from different regions or time periods to understand relative differences.
- These calculations help interpret real-world pandemic data critically and accurately.
Evaluating COVID-19 data involves calculating percentage change to see trends over time and percentage difference to compare values. These skills improve understanding of the pandemic’s impact and support informed decision-making.
